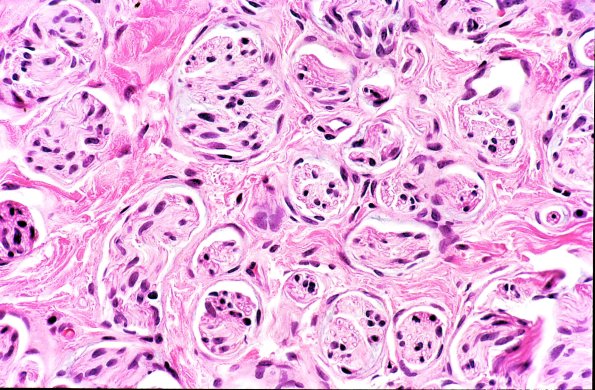
17A2 Neuroma, traumatic (Case 17) H&E 2

Table of Contents
Washington University Experience | PERIPHERAL NEUROPATHY | 19 TRAUMATIC INJURIES | 17A2 Neuroma, traumatic (Case 17) H&E 2
Sections show a peripheral nerve with 4-5 fascicles surrounded by numerous "mini-fascicles" in a collagenous background. (H&E)